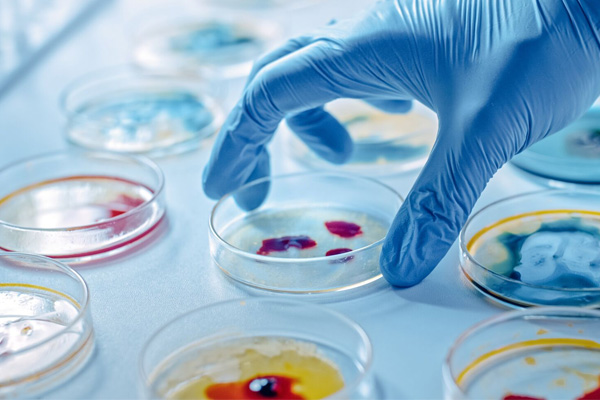

Pathology is the medical discipline that provides diagnostic information to patients and clinicians. It impacts nearly all aspects of patient care, from diagnosing cancer to managing chronic diseases through accurate laboratory testing.
CBC / Haemogram
Haemoglobin
ESR
Platelet Count
Bleeding & Clotting Time
Prothrombin Time
Malarial Parasites (M.P.)
Blood Group & RH factor
G-6 PD Estimation
Coomb's Test
Glycosylated Haemoglobin

Urine Routine / B.S.B.P.
Stool Routine
Sputum Routine / A.F.B.
Semen Analysis
Mantoux Test (M.T.)
Pregnancy Test (Strip Method)

Widal Test
R.A. Test (Qualitative / Quantitative)
C-Reactive Protein (Qualitative / Quantitative)
Rh Ntobody Titre
V.D.R.L. Test
HIV 1&2
Australia Antigen (HbsAg.)
Malaria Antigen Test
Malaria Antibody Test
Dengue NS1
Dengue NS1 IGG, IGM

Blood Sugar Fasting Random
Blood Sugar P.P. / P.G.
Glucose Tolerance Test (5 samples)
Serum Cholesterol
Serem H.D.L. Cholesterol (Direct)
Serum Triglyceride
Serum Urea / B.U.N.
Serum Uric Acid
Serum Creatinine
Serum Calcium
Serum Phosphorous
Serum Amylase
Serum Electrolyte (Na.K.Cl.)
Serum Proteins
Serum Alkaline Phosphatase
Serum Billirubin
SGOT
SGPT

Total Body Profile
Liver Function Test (L.F.T.)
Lipid Profile
Renal Profile
Hypertension Profile
Cardiac Injury Profile
SMA 12 + 2 Profile
Thyroid Profile (T3 t4 TSH)

Culture & Antibiotic sinsitivity of :
Urine
Stool
Sputum
Pus
Blood